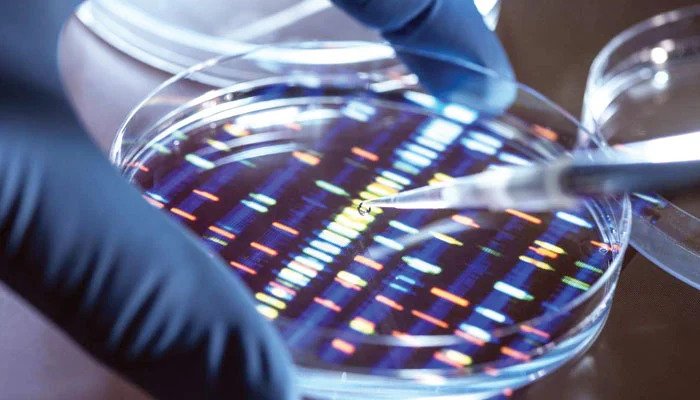
جینیات کے میدان میں پیش رفت
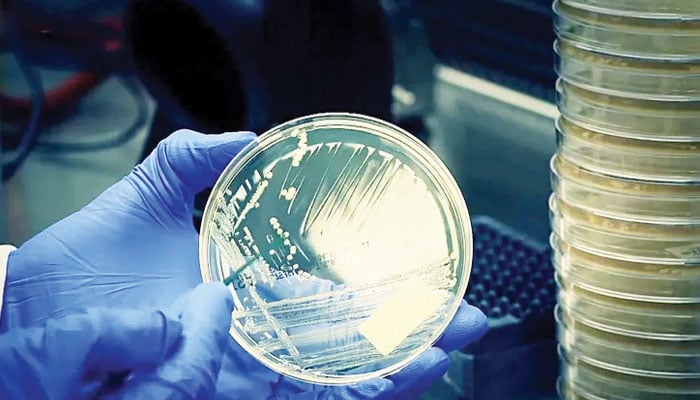
جینیات کے میدان میں پیش رفت

Tuesday / Jul 18 2023
Newspaper : The Daily Jung (اردو)
اس جدید دور میں ماہرین جینیاتی طور پر بات کرنے والی چوہے اور بندر تیار کر چکے ہیں، ا س کے ساتھ ساتھ جنگلی جانوروں میں تبدیلی اور عمر رسیدگی کے جین کی شناخت کرنا اور دیگر چیزوں کو تیار کرنے کے طریقے متعارف کروارہے ہیں۔ ان میں سے چند کے بارے میں ذیل میں بتا جارہا ہے۔
بات کرنے
والےچوہے اور
بندر
کیا چیز
انسانوں کو
منفرد خصوصیت
دیتی ہے۔ اگر
ایسا ہماری
جینیات کی وجہ
سے ہے تو
ہمارے جنیوم
کا وہ کون سا
حصہ ہے جو اس
میں حصہ لیتا
ہے، اور اگر
ہم یہ جینیاتی
تبدیلی
جانوروں میں
کرد یں تو کیا
وہ ہماری طرح
ایک دن کے
اندر ابلاغ
کرنے کے قابل
ہوجائیں گے۔
اس حوالے سے
اہم معلومات
کا انکشاف 1990ء
میں ایک
برطانوی
سائنس دان نے
کیا تھا جوکہ
ایک برطانوی
خاندان کےحوالے
سےتھا۔ اس
خاندان کے
تقریباً نصف
افراد شدید
قسم کے بولنے
اور زبان کے
مسئلے سے
دوچار تھے، جس
کی وجہ سے وہ
صحیح انداز
میں گفتگو
نہیں کرپارہے
تھے۔
آکسفورڈ میں
سائنسدانوں
کی کوششوں سے
یہ معلوم
ہواکہ اس نقص
کی وجہ ایک
ٹوٹ پھوٹ
کاشکار جین
ہے۔
اب اس جین
کو
(language gene) یازبان
کاجین
کہاجاتاہے
۔جرمنی
کےمیکس پلانک
انسٹی ٹیوٹ
برائےارتقائی
علم البشریات
میں کام
کرنےوالی ٹیم
نےحال ہی میں
ایک چوہےکی
پرورش کی ہے،
جس کے جین میں
شکل تشکیل
دینےکی
صلاحیت ہے ۔
اس کا نتیجہ
حیران کن ہے۔
اس چوہے کے
اندر کلی طور
پر مختلف آوازیں
نکالنے کی
صلاحیت موجو د
ہے۔ اس
کےعلاوہ اس کے
ذہن میں
سمجھنے کی
گنجائش
سےکہیں زیاد ہ
سیکھنے کی
صلاحیت بھی
موجود ہے۔
یہ خیال
کیاجاتا ہےکہ
جین دماغ کے
اندر بعض ضروری
صلاحیتیں
پیدا کردیتا
ہے اور
ہونٹوں، زبان،
پھیپھڑے اور
حلق کے درمیان
میں وہ تعلق
قائم کرتا ہے
جو بولنے کے
عمل کے لیے
ضروری ہے۔ اگر
یہ دماغ کے ان
افعال کو اس
قدر بڑھانے
میں کامیاب
ہوجائےجو
خیالات کی
تشکیل کے لیے ضروری
ہیں اور جو
بعد میں گفتگو
میں تبدیل ہوجاتے
ہیں تومستقبل
میں ہمیں
بولنے والی
بلیاں، کتے،
چوہے اور بندر
مل سکتے ہیں۔
جینیاتی
طور پر جنگلی
جانوروں کو
سدھانا
بعض لوگ
دوسروں
کےمقابلے میں
زیادہ جارحیت
پسند ہوتے
ہیں۔ اس کی
وجہ یہ ہوتی
ہے کہ اس قسم کے
رجحان انھیں
مجرمانہ
سرگرمیوں کی
جانب لے جاتے
ہیں۔ یہی حال
جانوروں کا
ہےکہ بعض
جانوراپنی
اندرونی
خصوصیات کی
وجہ سےگھریلو
طور پر سدھائے
نہیں جاسکتے۔
ان جانوروں
میں بھیڑیا،
لومڑی، لنگور،
زیبرا، چیتا
اور دوسرے
جانور شامل ہیں
۔1970ءمیں روس
میں قائم
ادارے میں
برائے علم
الخلویات اور
جینیات (Institute of Cytology and Genetics) میں
ایک دلچسپ
تجربہ کیا
گیا۔ چوہوں کے
دو گروپ ایک
کے بعد دوسری
نسل سے لے کر
جارحانہ اور سدھا
ئےوالی
خصوصیات کے
حوالے سے
علیحدہ کیے گئے۔
اس قسم کے
باربار
دہرائے
جانےوالےانتخاب
کے30 سال گذرنے
کے بعد دونوں
گروہوں
نےحیران کن
مختلف رویوں
کا اظہار کیا۔
سدھانے
والے گروپ نے
سدھائےجانےکی
انتہائی صلاحیت
کا
اظہارکیا،جب
کہ جن کی
جارحانہ مزاج
کےحوالے سے
نشوونما کی
گئی تھی وہ
انتہائی جنگلی
ثابت ہوئے۔ اس
سےیہ واضح
ہوتا ہے کہ اس
کےذمہ داربعض
جین ہیں۔ اسی
طرح کا ایک اور
تجربہ سفید
لومڑی کی آٹھ
نسلوں میں کیا
گیا اور ایک
نئی قسم کی
سفید لومڑی
حاصل ہوئی جو
اپنے جارحانہ
رجحانات سے
محروم ہوچکی
تھی۔ انسانوں
میں پر تشدد
جرائم کے
رجحان کو کم
کرنے کا حل
جینیات کے پاس
ہے، یہ ان جین
کی شناخت کے
ذریعے کیا جا
سکتا ہے جو ان
رجحانات کا
باعث بنتے ہیں
اور پھر ان سے
جین تھراپی یاجینیاتی
علاج کے ذریعے
نبرد آ زما
ہوناممکن
ہوسکتا ہے۔

زراعت میں
جینیات کی
اہمیت
حرارت میں
اضافے سے دنیا
کے کئی ممالک
جن میں پاکستان
بھی شامل ہے
،ان میں قحط
اور خشک سالی
کا خطرہ ہے ۔
جینیات کے
میدان میں
ہونے والی پیش
رفت نے اُمید
کی کرن پیدا
کی ہے ۔
جینیاتی انجینئر
فصلوں کی
مددسےنہ صرف
غلہ کی
پیداوار میں
اضافہ
ہوتاہےبلکہ
زیادہ غذائیت
کی حامل فصلیں
اور بیماریوں
سے مزاحم
فصلیں حاصل
ہورہی ہیں۔ اس
حوالے سے تازہ
ترین پیش رفت کیڑوں
سے مزاحم
گوار،
پھپھوند سے
مزاحم کیلے،
وائرس سے
مزاحم
شکرقندی،
زیادہ غلہ کی
حامل باجرے کی
فصل اورخشک
سالی شامل ہے۔
اس کے علاوہ
بھی جینیاتی
انجینئرنگ کے
ذریعے فصلوں کی
بے شمار اقسام
تیارکرلی گئی
ہیں ۔ لیکن ا گر
اس کے حفاظتی
تقاضوں کو
پورا کرلیا
جائے تو ان
فصلوں کی
افزائش میں
خوف کی کوئی
بات نہیں ہے،
بلکہ ان کی
مدد سے ہم
آنے والے
غذائی بحران
سے بہتر طریقے
سے نمٹ سکیں
گے۔
تشدد پر
مائل مجرموں
کےلیےکرائم
جین
میری لینڈ
امریکا کے
نیشنل
انسٹیٹیوٹ
میں کام
کرنےوالےڈیوڈگولڈ
مین اور ان کے
ساتھیوں نے
ایک جین دریافت
کی ہے جوکہ
مجرموں میں
مجرمانہ رویہ
کا باعث بنتی
ہے۔ اس جین کو
مجرموں کے
جینیاتی پروفائل
کے مطالعہ کے
بعد شناخت کیا
گیا۔ یہ جین سیروٹونین
کی تشکیل میں
رکاوٹ پیدا
کرتا ہے، جو
کہ دماغ کے اس
حصے پر اثر
انداز ہوتا ہے
جو مجرموں کو
جرم کےنتائج
سے آگاہ کرکے
جرم سےبازرکھتاہے۔
اس جین کی
موجدگی تشدد
کی موجودگی کو
ظاہر کرتی ہے
، مگراس
کامطلب یہ
نہیں ہے کہ اس
جین کےحامل
تمام
افرادایک ہی
قسم کےرویہ کا
اظہار کریں
گے۔
ناپیدقدیم
جانوروں کی
کلوننگ
کلوننگ کی
ٹیکنالوجی
انتہائی تیز
رفتاری کےساتھ
آگے بڑھ رہی
ہے اوراس میں
روز بروز نئی دریافتیں
سامنےآرہی
ہیں، اس
ٹیکنالوجی کی مدد
سے اب قدیم
ناپید
جانوروں کی
کلوننگ کا خواب
حقیقت میں
تبدیل ہونے
جارہا ہے ۔ یہ
حقیقت اس وقت
سامنےآئی جب
کوبے (Qubay) ،جاپان
کے سینٹر
برائے
ترقیاتی
حیوانیات نے کامیابی
کے ساتھ ایک
چوہےکی
بافتوں (tissues) کواستعمال
کرتے ہوئے
دوبارہ چوہا
تیار کیا، جس
کو سولہ سال
قبل جمایا گیا
تھا۔ اسی
تیکنیک کو
میمتھ کی
کلوننگ کے لیے
بھی اختیار
کیا جا رہا ہے
۔ میمتھ کی
نسل
ساڑھےچارہزارسال
قبل ختم ہوگئی
تھی، مگران کی
باقیات
سائبریا کی
برف میں دفن
ہیں ۔ اس
جاپانی گروپ
نے میمتھ
کےانڈے کے
نیوکلیائی
تیار کرنےمیں
کامیابی حاصل
کرلی ہے۔
عمررسیدگی
کےجین کی
شناخت
کنگ کالج
لندن کے
محققین نےبعض
ایسے جین کی
شناخت کی ہے
جوانسانوں
میں عمر
رسیدگی کا
باعث بنتی ہیں
۔ انہوں نے
انکشاف کیا ہے
کہ ان جین کے افعال
کو بعض بیرونی
عوامل مثلاً
غذا اور ماحول
کے ذریعے
کھولا اور
بندکیا جا
سکتا ہے اور ان
کے پاس لمبی
صحت مندزندگی
کی کلید ہے
،یہ انکشاف
مختلف عمروں
کے حامل کئی
سو جڑواں
بچوں،
آدمیوں
اورعورتوں
میں جینیاتی یکسانیت
اورفرق کے
جائزے کے بعد
کیا گیا ہے۔
تحقیق کے
مطابق وہ چار
اہم جین جوصحت
مند بڑھاپے
اور طویل عمر
پر اثر ڈالتے
ہیں
کولیسٹرول
اور پھیپھڑوں
کے افعال سے
بھی منسلک
ہیں۔ اس تحقیق
نے عمر رسیدگی
کے حوالے سے
اہم معلومات
فراہم کی ہیں
اور عمر
رسیدگی کے
خلاف علاج کے حوالے
سے کئی نئے
دروازے کھولے
ہیں۔
" سیاہ
موت " کی جینوم
درجہ بندی
1330ءاور1347ءکےدرمیان
ایک مہلک
وبائی مرض
" طاعون" کی وجہ
سے دنیا کی
ایک تہائی
آبادی ہلاکت
کا شکار ہوگئی
تھی ، اسی وجہ
سےاس بیماری
کو "سیاہ
موت" یا "Black Death" کا نام دیا
گیا تھا۔ کہا
جاتا ہے کہ یہ
بیماری1330 کی
دہائی میں
ایشیا کے
شمالی حصوں سے
ابھری تھی اور
4091ء کی دہائی
میں یہ
وبایورپ
پہنچی، جس نے پوری
دنیا میں
تقریباً 57
ملین
(ساڑھےسات
کروڑ) افراد کو
ہلاک کردیا
تھا۔

وزن کم کرنے
کی سائنس
ہمارے کرۂ
ارض پر بسنے
والے افراد کی
ایک بڑی تعداد
موٹاپے کا
شکار
ہے۔عالمی
ادارہ صحت کے مطابق
دنیا میں
تقریباً 2کروڑ
(2بلین) افراد
وزن کی زیادتی
یا موٹاپے کا
شکار ہیں جو
کہ دنیا کی
آبادی کی ایک
تہائی تعداد
ہے۔ اس کے کئی
اسباب سامنے
آئے ہیں، جن
میں جینیاتی
سبب بھی شامل
ہے۔ اس کے
مطابق ایک
موٹاپے کا جین Obesity gene جس کو FTO کہا جاتا
ہے، موٹاپا
پیدا کرنے کا
باعث ہے۔
یہ جین
یورپیوں
کی61فی صد
آبادی میں
پایا جاتا ہے۔
موٹاپے کی ایک
اور وجہ نیند
میں کمی ہے۔ اس
سے آپ حیران
ہوں گے کہ
جاگنے کی حالت
میں آپ زیادہ
کیلوریز خرچ
کرتے ہیں تو
نیند میں کمی
کی وجہ سے تو
وزن کم ہونا
چاہیے، مگر
حقیقت اس کے
برعکس ہے۔
امریکا میں Disease Control and Prevention کے
مرکز میں 78,000
امریکیوں پر
ایک تحقیقی
مطالعہ کیا
گیا، جس سے یہ
معلوم ہوا کہ
وہ لوگ جو6
گھنٹے سے کم
کی نیند لیتے
ہیں ان کی 33فی
صدتعداد
موٹاپے کی طرف
مائل ہے۔
اس سے قبل
کیے جانے والے
مطالعہ جات سے
یہ ظاہر ہوا
ہے کہ بعض
بھوک کو منظم
کرنے والے
ہارمون (ghrelin and leptin) نیند
کی کمی سے
متاثر ہوتے
ہیں اور یہی
بھوک میں
اضافہ کا سبب
بنتے ہیں اور
انسان میں
نمکین اور
میٹھی غذاؤں
کی خواہش پید
اہوتی ہے۔ اس
حوالے سے بعض
ماحولیاتی
عوامل کی بھی
شناخت ہوئی
ہے۔ ان میں سے
ایک (Bisphenol A) BPA بھی ہے، جو
کہ پلاسٹک کے
تھیلوں،
کھلونوں، ٹوتھ
برش اور پانی
کی بوتلوں میں
پایا جاتا ہے۔
یہ خیال
کیا جاتا ہے
کہ ایک قدرتی
ہارمون اسٹروجن
کے افعال کی
نقل کرتا ہے
اور موٹاپے کے
خلیات یا fat cell کو
ترتیب دینے
والے میکنزم
کو تیار کرتا
ہے۔امریکا
میں قائم Purdue یونیورسٹی
کے پروفیسر
ٹیری ڈیوڈسن
نے یہ انکشاف
کیا ہے کہ
چوہوں کو اگر
مصنوعی مٹھاس
دی جائے تو ان
کے وزن میں
تیزی سے اضافہ
ہوتا ہے اور
ہمارے جسم میں
کیلوریز کی
تعداد کے
قدرتی میکنزم
میں مداخلت
بھی کرتی ہے۔Brown
fat جو کہ
ایک قسم کے
پروٹین thermogenin کا
حامل ہوتا ہے۔
کیلوریز کو
تیزی سے جلاتا
ہے، مگر جیسے
جیسے ہماری
عمر بڑھتی ہے
یہ کم ہونے
لگتا ہے اورجب
عمر 40 سے زیادہ
ہو جاتی ہے تو
بالکل ختم ہو جاتا
ہے۔ محققین اس
کو عام چکنائی
سے حاصل کرنے
کے طریقے تلاش
کررہے ہیں۔
.یہ مصنف ایچ ای سی کے سابق صدر اور او ایس سی ممالک (سائنس) کے سائنس دانوں کے نیٹ ورک آفس کے صدر ہیں